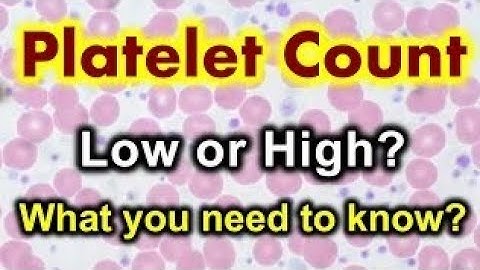
PLATELET COUNT MANUALLY,manual platelet count, platelet,thrombocyte count#drnajeeb #science #health
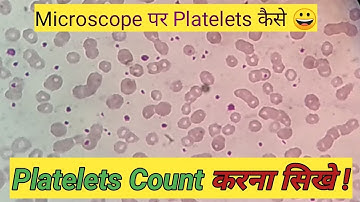
Manual platelet count slide method | Platelets count on smear

⬇ DOWNLOAD NOW
Kalau muncul iklan pop-up, tutup lalu klik tombol kembali
Download lagu Platelets Count || Manual method || Neubauer chamber #Platelets#PlateletCount#HealthAwareness#tips secara gratis hanya untuk keperluan promosi. Dukung artis favorit kamu dengan membeli musik original di iTunes atau platform resmi lainnya.
 Platelet count by simple manually slide method || Hematology
Platelet count by simple manually slide method || Hematology
 Manual platelet count - hemocytometer Procedure | Calculation | interpretation
Manual platelet count - hemocytometer Procedure | Calculation | interpretation
 Manual Platelets count formula | Platelets count under microscope | Low Platelets | High Platelets
Manual Platelets count formula | Platelets count under microscope | Low Platelets | High Platelets
 Platelet Count || Complete Lecture with Practical by neubauer chamber in hindi ||
Platelet Count || Complete Lecture with Practical by neubauer chamber in hindi ||
PLATELET COUNT MANUALLY,manual platelet count, platelet,thrombocyte count#drnajeeb #science #health
PLATELET COUNT MANUALLY,manual platelet count, platelet,thrombocyte count#drnajeeb #science #health
Manual platelet count slide method | Platelets count on smear
Manual platelet count slide method | Platelets count on smear
 Manual platelet count slide method|Platelets count of Slide Method|platelets Count #platelets #lab
Manual platelet count slide method|Platelets count of Slide Method|platelets Count #platelets #lab
 Practical guide for counting of blood platelets !!!
Practical guide for counting of blood platelets !!!